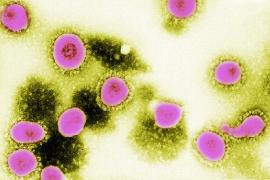
Particule moarte de COVID-19, responsabile pentru testele pozitive la pacienții vindecați

Știri teste covid
Citeste ultimele stiri pe Observator despre Teste Covid. Fii informat cu Observatornews.ro, site de stiri care prezinta cele mai noi informatii, reportaje si evenimente din tara si din lume.
Citeste ultimele stiri pe Observator despre Teste Covid. Fii informat cu Observatornews.ro, site de stiri care prezinta cele mai noi informatii, reportaje si evenimente din tara si din lume.

Kremlinul confirmă faptul că fostul preşedinte american Donald Trump i-a trimis în secret teste COVID lui...
pe 10.10.2024 la 11:20
China dă, din nou, motive de panică Occidentului. Beijingul declară că a învins pandemia de coronavirus, chiar...
pe 04.01.2023 la 13:52
S-a decis: teste Covid obligatorii pentru cei care sosesc în Italia din China. Totul după ce pasagerii a două zboruri...
pe 28.12.2022 la 22:10
Medicul Virgil Musta, şef de secţie la Spitalul Clinic de Boli Infecţioase din Timişoara, a fost trimis în judecată de...
pe 29.11.2022 la 13:15
Metropola chineză Chongqing a organizat o testare Covid în masă în zona centrală. Milioane de locuitori au fost...
pe 25.08.2022 la 15:30
Autorităţile din Shanghai au ordonat testarea în masă pentru două milioane de locuitori într-o zonă a oraşului...
pe 09.06.2022 la 13:47
Israelul a anunțat duminică că pune capăt testelor obligatorii COVID-19 pentru sosirile la aeroportul Ben Gurion din Tel Aviv,...
pe 08.05.2022 la 16:40
Mii de medici de familie care au făcut teste COVID pacienţilor se plâng că nu şi-au primit banii de la stat şi...
pe 18.04.2022 la 21:00
Ministrul Educaţiei, Sorin Cîmpeanu a anunţat, miercuri, în şedinţa Executivului, că astăzi au fost repartizate...
pe 02.02.2022 la 14:30
Secretarul de stat la Ministerul Sănătăţii, Adriana Pistol, a afirmat că testarea copiilor de două ori pe săptămână...
pe 29.01.2022 la 21:49
Un număr de 26.974 de elevi şi preşcolari - reprezentând 0,93% din total - sunt infectaţi cu noul coronavirus, iar 108...
pe 28.01.2022 la 18:23
Cele 27 de state membre UE au convenit marţi să-şi coordoneze mai bine regulile cu privire la deplasări în interiorul Uniunii...
pe 25.01.2022 la 18:38
Ministerul Sănătăţii a decis înfiinţarea de centre de recoltare pentru pacienţi cu simptome de COVID-19 la mai multe spitale...
pe 23.01.2022 la 11:22
Testarea elevilor, eşec în formă continuată. Pentru joi, deja nu mai există teste în şcoli, iar de la autoritati nicio veste....
pe 04.01.2022 la 20:59
A doua săptămână de testare rapidă a elevilor a început cu stângul. Pentru că nu au ajuns la timp kiturile, autorităţile...
pe 13.12.2021 la 20:45
Consiliul Naţional al Elevilor reclamă "inconsecvenţa în măsuri" după ce reprezentanţii Ministerului Educaţiei au anunţat...
pe 09.12.2021 la 07:15
Şeful Departamentului pentru Situaţii de Urgenţă, Raed Arafat, a afirmat, vineri seară, că testele pe bază de salivă...
pe 03.12.2021 la 22:30
Raed Arafat a declarat că Departamentul pentru Situaţii de Urgenţă are atribuţii stabilite prin lege şi niciodată ”nu se...
pe 03.12.2021 la 22:00
Ministrul Educaţiei anunţă că primele teste rapide din salivă pentru depistarea infecţiei cu SARS-CoV-2 vor ajunge joi în...
pe 25.11.2021 la 14:20
Certificatul sanitar COVID-19 devine obligatoriu începând de vineri în Italia pentru toţi angajaţii, atât în sectorul public...
pe 15.10.2021 la 10:05
Acuzaţii grave făcute de fostul ministru al sănătăţii, Vlad Voiculescu. Peste patru mii de teste pozitive ar fi dispărut din...
pe 26.09.2021 la 21:12
Medicul Oana Nicolescu, şefa DSP Bucureşti, a comentat pentru News.ro, afirmaţiile fostului ministru al Sănătăţii Vlad...
pe 26.09.2021 la 18:21
Alternativă pentru testul PCR, prezentată în premieră la Timişoara! Un test de mare precizie, dar şi mai rapid şi accesibil....
pe 25.09.2021 la 08:27
Ponderea cea mai mare din numărul de persoane care au înregistrat un rezultat pozitiv la COVID în ultimele 2 săptămâni este...
pe 17.09.2021 la 17:47
Autorităţile din oraşul chinez Wuhan au anunţat că au încheiat vasta operaţiune de depistare covid-19, organizată după o...
pe 09.08.2021 la 12:18
Ministrul Sănătăţii, Ioana Mihăilă, a declarat, vineri, la Timişoara, că, pentru a accelera procesul de identificare a...
pe 07.05.2021 la 11:23
Un bărbat care vindea cu 150 de lei rapoarte false de analiză pentru teste negative de COVID-19 a fost ridicat de poliţişti,...
pe 22.04.2021 la 11:51
Trei elevi din orașul elvețian Basel au falsificat rezultatele testelor COVID pentru a scăpa de școală. Însă farsa lor a avut...
pe 08.04.2021 la 11:27
Guvernul britanic promite teste COVID-19 gratuite, de două ori pe săptămână, pentru toată lumea din Anglia, începând de...
pe 05.04.2021 la 06:56
De mai bine de un an, statul face exerciţii de "drepţi-culcat" cu industria HoReCa - şi nu numai, desigur. Ba se închid, ba se...
pe 03.04.2021 la 14:36
Turcia anunţă că nu le va impune dovezi privind vaccinarea turiştilor străini. După 15 aprilie, autorităţile turce vor...
pe 15.03.2021 la 17:09
Chiar dacă ne confruntăm de mai bine de un an cu acelaşi virus, strategiile au fost diferite. Unele judeţe s-au înroşit, în...
pe 28.02.2021 la 09:37
Teste anti-Covid obligatorii şi certificate de vaccinare. Aşa se va putea intra pe stadion la meciurile care vor fi pe Arena...
pe 23.02.2021 la 23:30
În ultimul an s-au schimbat chiar şi recompensele pe care angajatorii le dau angajaţilor pentru a-i fideliza. Acum decontează...
pe 23.02.2021 la 20:42
După haosul produs la sfârşitul anului trecut în sudul Angliei, la Dover, când mii de şoferi de TIR au fost blocaţi zile în...
pe 16.02.2021 la 06:51
A fost actualizată din nou lista ţărilor cu risc epidemiologic ridicat şi s-a dublat numărul statelor pentru care turiştii...
pe 04.02.2021 la 20:10
Alexandru Rafila, reprezentantul OMS în România, a făcut declaraţii despre cel mai recent bilanţ al deceselor Covid din...
pe 02.12.2020 la 07:49
Peste 80% dintre persoanele diagnosticate cu coronavirus nu au avut simptome cheie la momentul depistării infecției, arată un...
pe 08.10.2020 la 13:37
Bărbatul din Slatina a fost externat sâmbătă de la Spitalul Județean din Slatina, după ce și al doilea test de coronavirus...
pe 03.08.2020 la 08:17
Sunt sau nu reale rezultatele testelor făcute în ultima perioadă? Era ultima îndoială de care aveam nevoie în epidemia de...
pe 29.07.2020 la 21:05
Pentru că au epuizat testele COVID, cadrele medicale din Galaţi au ajuns să alunge din spital oamenii care vin să afle dacă...
pe 25.07.2020 la 10:30
Ministerul Afacerilor Externe (MAE) a anunțat că, din 15 iulie, românii care vor să intre pe teritoriul Ungariei vor fi plasați...
pe 12.07.2020 la 16:33
Oficialii din domeniul sănătății din Coreea de Sud au declarat că pacienții vindecați de coronavirus, care ulterior au ieșit...
pe 01.05.2020 la 12:23
Primarul din Craiova critică algoritmul testărilor de COVID-19 stabilit de Ministerul Sănătății și susține că multe teste...
pe 29.04.2020 la 10:47